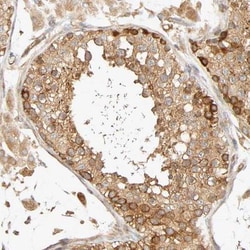
SGSM1 Antibody, Novus Biologicals:Antibodies:Primary Antibodies

missing translation for 'onlineSavingsMsg'
Learn More
Learn More
SGSM1 Antibody, Novus Biologicals™
Rabbit Polyclonal Antibody
€ 415.00 - € 572.00
Specifications
| Antigen | SGSM1 |
|---|---|
| Dilution | Immunohistochemistry, Immunohistochemistry-Paraffin 1:20 - 1:50 |
| Applications | Immunohistochemistry, Immunohistochemistry (Paraffin) |
| Classification | Polyclonal |
| Conjugate | Unconjugated |
| Product Code | Brand | Quantity | Price | Quantity & Availability | |||||
|---|---|---|---|---|---|---|---|---|---|
| Product Code | Brand | Quantity | Price | Quantity & Availability | |||||
|
18434351
|
Novus Biologicals
NBP1-93564-25ul |
25 μL |
€ 415.00
25µL |
Please sign in to purchase this item. Need a web account? Register with us today! | |||||
|
18055677
|
Novus Biologicals
NBP1-93564 |
0.1 mL |
€ 572.00
0.10mL |
Please sign in to purchase this item. Need a web account? Register with us today! | |||||
Description
SGSM1 Polyclonal specifically detects SGSM1 in Human samples. It is validated for Immunohistochemistry, Immunohistochemistry-Paraffin.Specifications
| SGSM1 | |
| Immunohistochemistry, Immunohistochemistry (Paraffin) | |
| Unconjugated | |
| RUO | |
| PBS (pH 7.2) and 40% Glycerol with 0.02% Sodium Azide | |
| 129049 | |
| This antibody was developed against Recombinant Protein corresponding to amino acids:SPDSGHPSSHNFSSGLSEHSEPSLSTEDSVLDAQRNTPTVLRPRDGSVDDRQSSEATTSQDEAPREELAVQDSLESDLLANESMDEFMSITGSLDMALPEKDDVVMEGWRSSETEKHGQADSEDNLSEEPEMESLFPALASLAVTT | |
| Primary | |
| Store at 4C short term. Aliquot and store at -20C long term. Avoid freeze-thaw cycles. |
| Immunohistochemistry, Immunohistochemistry-Paraffin 1:20 - 1:50 | |
| Polyclonal | |
| Rabbit | |
| Human | |
| RUN and TBC1 domain-containing protein 2, RUTBC2, small G protein signaling modulator 1, small G protein signaling modulator 1 protein | |
| SGSM1 | |
| IgG | |
| Affinity Purified | |
| Specificity of antibody verified on a Protein Array containing target protein plus 383 other non-specific proteins. |
For Research Use Only
Spot an opportunity for improvement?Share a Content Correction
Product Content Correction
Your input is important to us. Please complete this form to provide feedback related to the content on this product.
Product Title